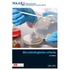
Microbiologische criteria

Welcome to Boeklezers.nl
Boeklezers.nl is a network for social reading. We help readers discover new books and authors, and bring readers in contact with each other and with writers. Read more ».
Books
Microbiologische criteria
Microbiologische criteria maakt deel uit van reeks Praktijkgidsen
Waar&Wet en behandelt grenswaarden voor microbiologische voedselveilig
heidscriteria en voo... »
Microbiologische criteria maakt deel uit van reeks Praktijkgidsen
Waar&Wet en behandelt grenswaarden voor microbiologische voedselveilig
heidscriteria en voo... »
Houdbaarheid van voedingsmiddelen
Houdbaarheid van voedingsmiddelen
Houdbaarheid is een van de belangrijkste thema's binnen de voedings-middelenindustrie. Door de toenemende vraag naar voedse... »
Houdbaarheid van voedingsmiddelen
Houdbaarheid is een van de belangrijkste thema's binnen de voedings-middelenindustrie. Door de toenemende vraag naar voedse... »
Houdbaarheid van voedingsmiddelen
Houdbaarheid is een van de belangrijkste thema's binnen de voedingsmiddelenindustrie. Door de toenemende vraag naar voedsel met een langere houdbaarheid is e... »
Houdbaarheid is een van de belangrijkste thema's binnen de voedingsmiddelenindustrie. Door de toenemende vraag naar voedsel met een langere houdbaarheid is e... »